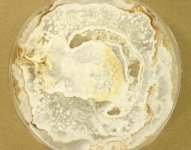

<< back to search
IMAGES:





Search Details
add to cart
| UAMH Number: | 11652 |
|---|---|
| Species Name: | Lentinus brumalis |
| Type: | |
| Synonyms: | Boletus brumalis / Boletus brumalis var. fasciculatus / Boletus ciliatus / Boletus fasciculatus / Boletus fuscidulus / Boletus hypocrateriformis / Boletus umbilicatus / Favolus apiahynus / Leucoporus brumalis / Leucoporus fuscidulus / Leucoporus vernalis / Microporus substriatus / Polyporellus brumalis / Polyporellus fuscidulus / Polyporus brumalis / Polyporus cyathoides / Polyporus fuscidulus / Polyporus luridus / Polyporus nanus / Polyporus pauperculus / Polyporus queletianus / Polyporus subarcularius / Polyporus substriatus / Polyporus trachypus / Polyporus tucumanensis / Polyporus vernalis / Polystictus brumalis / Polystictus substriatus |
| Taxonomy: | FUNGI Basidiomycota, Agaricomycetes, Polyporales, Polyporaceae |
| Strain History: | Tudor, D (DT1023) -> UAMH |
| Substrate: | on unidentified dead hardwood log | Location: | CANADA Ontario, King City, Koffler Scientific Reserve at Jokers Hill (GEO: 44.03,-79.532) |
| Isolator: | D. Tudor |
| Isolation Date: | 2010-10-01 |
| Date Received: | 2012-07-26 |
| Characters: | BIODETERIOGEN/ BIODEGRADATION influence of pH on pigment formation by lignicolous fungi - Tudor D, Robinson SC, Cooper PA, Int Biodeter Biodegrad 80:22-28, 2013 // CULTURE CONDITIONS clamps - (Click for publications citing UAMH 11652) |
| Compounds: | |
| Cross Reference: | TRTC 167759 |
| Collections: | Living Strains; Dried Herbarium Material |
| Pathogenic Potential: | Human: no | Animal: no | Plant: no |
| Biosafety Risk Group: | RG1 (check the PHAC ePATHogen Risk Group Database for updates) |
| Regulatory Requirements: | No restrictions for Canadian requesters. International requesters must provide all legally required importation documentation prior to shipment. Plant pathogenicity status may be verified by using the USDA Agricultural Research Service (ARS) Fungal Database |
| MycoBank ID: | 543133 |
| Sequences: | >UAMH11652_JX843718 CATTATCGAGTTCTGAAACGGGTTGTAGCTGGCCTTCCGAGGCATGTGCACGCCCTGCTCATCCACTCTACACCTGTGCACTTACTGTGGGTTTCAGGAGCTTCGAAGCGAGTGCTTAACCGCTCTCGCCGAGTTGTTACTGGGCCTACGTTTATCACAAACTCTTAAAGTATCAGAATGTAAACGCGTCTAACGCATCTATATACAACTTTCAGCAACGGATCTCTTGGCTCTCGCATCGATGAAGAACGCAGCGAAATGCGATAAGTAATGTGAATTGCAGAATTCAGTGAATCATCGAATCTTTGAACGCACCTTGCGCTCCTTGGTATTCCGAGGAGCATGCCTGTTTGAGTGTCATGAAATTCTCAACCTAACAGGTTCTTAACGGGACTTGCTTAGGCTTGGACTTGGAGGCTTGTCGGCTGCTTAGCAGTCGGCTCCTCTCAAATGCATTAGCTTGGTTCCTTGCGGATCGGCTCACGGTGTGATAATTATCTGCGCCGCGACCGTTGAAGCGTTTAATGGCCAGCTTCTAATCGTCTCTTGCGAGACAGCTTTCATCGAACTCTGACCT |
IMAGES: